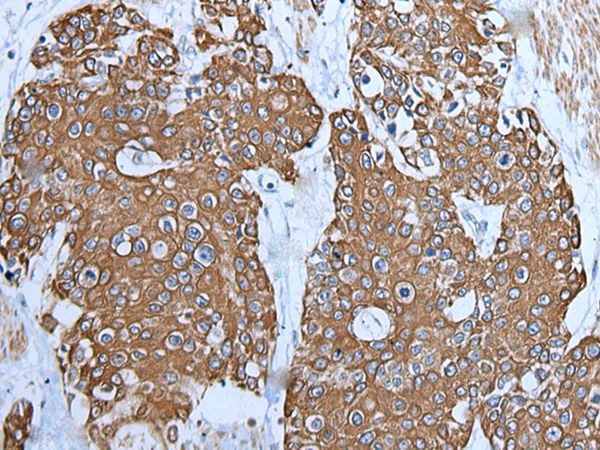
TRPC5 Antibody in Immunohistochemistry (Paraffin) (IHC (P))

Search
Invitrogen
TRPC5 Polyclonal Antibody
{{$productOrderCtrl.translations['antibody.pdp.commerceCard.promotion.promotions']}}
{{$productOrderCtrl.translations['antibody.pdp.commerceCard.promotion.viewpromo']}}
{{$productOrderCtrl.translations['antibody.pdp.commerceCard.promotion.promocode']}}: {{promo.promoCode}} {{promo.promoTitle}} {{promo.promoDescription}}. {{$productOrderCtrl.translations['antibody.pdp.commerceCard.promotion.learnmore']}}


Please note: We are reviewing Western blot images included in the antibody testing data in our catalog, including those provided by third parties. Unless expressly labeled or annotated as “raw-unedited”, Western blot images included in the antibody testing data in our catalog may have been edited, optimized or otherwise adjusted for presentation.
产品信息
PA5-67556
种属反应
宿主/亚型
分类
类型
抗原
偶联物
形式
浓度
规格
纯化类型
保存液
内含物
保存条件
运输条件
RRID
产品详细信息
Predicted to react with Mouse samples.
靶标信息
TRPC5 belongs to the transient receptor family. TRPC5 is one of the seven mammalian TRPC (transient receptor potential channel) proteins. The TRPC5 protein is a multi-pass membrane protein and is thought to form a receptor-activated non-selective calcium permeant cation channel. TRPC5 is active alone or as a heteromultimeric assembly with TRPC1, TRPC3, and TRPC4. TRPC5 also interacts with multiple proteins including calmodulin, CABP1, enkurin, Na(+)-H+ exchange regulatory factor (NHERF ), interferon-induced GTP-binding protein (MX1), ring finger protein 24 (RNF24), and SEC14 domain and spectrin repeat-containing protein 1 (SESTD1). TRPC5 is thought to form a receptor-activated non-selective calcium permeant cation channel. TRPC5 is probably operated by a phosphatidylinositol second messenger system activated by receptor tyrosine kinases, or G-protein coupled receptors. TRPC5 has also been shown to be calcium-selective, and may also be activated by intracellular calcium store depletion. Diseases associated with TRPC5 include Hypertrophic Pyloric Stenosis and Pyloric Stenosis.
仅用于科研。不用于诊断过程。未经明确授权不得转售。
篇参考文献 (0)
生物信息学
蛋白别名: Capacitative calcium entry channel 2; CCE2; Htrp-5; mtrp5; Short transient receptor potential channel 5; Transient receptor protein 5; TRP-5; Trp-related protein 5; TrpC5; vtransient receptor potential cation channel, subfamily C, member 5
基因别名: CCE2; TRP-5; TRP5; TRPC5; Trrp5
UniProt ID: (Mouse) Q9QX29
Entrez Gene ID: (Mouse) 22067